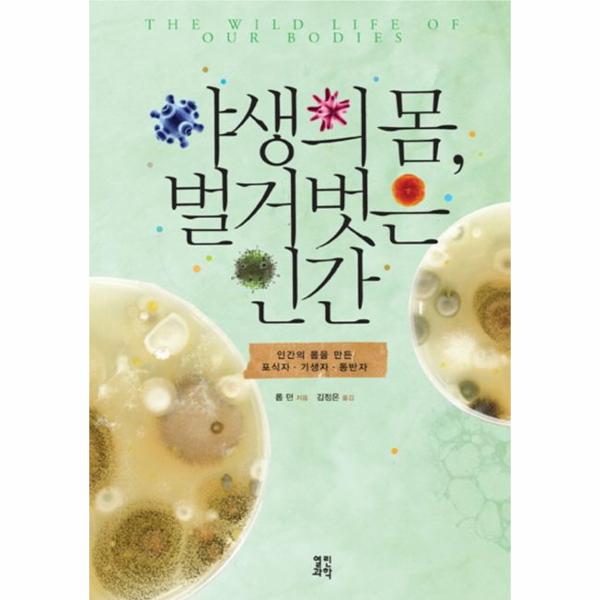

들어가는 말
제 1부 인류의 기원과 생명의 진화
제 2부 우리 몸에 기생충이 필요한 이유
02 건강한 몸이 쇠약해지는 까닭은?
03 위생 가설과 면역계의 기능
04 기생충을 몸속에 집어넣다
제 3부 우리 몸속의 미생물이 하는 일
05 파스퇴르의 의문과 레이니어스의 무균실
06 우리 몸과 미생물의 공생
제 4부 소가 우리를 살찌게 하는 이유
07 소가 인간을 길들이다
08 우유와 유전적 다양성
제 5부 우리는 어떻게 공포와 전율을 느끼게 되었을까?
09 우리는 모두 사냥을 당했다
10 도피에서 공격으로
11 인간의 시각은 뱀에 의해 진화되었다
12 어떤 종을 살릴지 선택하기
제 6부 질병은 어떻게 우리의 행동과 문화에 영향을 미쳤을까?
13 이와 진드기가 우리를 벌거숭이로 만들었을까?
14 외국인 혐오증과 집단주의 문화를 남긴 병원균
제 7부 인간 본성의 미래
15 옥상정원과 수경재배
찾아보기
우리 몸에 기생충이 필요한 이유, “진화는 불필요한 설계를 하지 않는다.”
현대문명이 고도로 발달한 사회 일수록 인류가 이전에 전혀 경험해 보지 못한 새로운 질병에 고통 받고 있다. 각종 암과 이제 그 종류를 헤아리기도 쉽지 않은 ‘자가면역질환’이 그것 들이다. 미국의 존스홉킨스 의과대학의 노엘 로스 박사Dr. Noel Rose에 의하면 자가면역질환은 이제 그 종류가 무려 80여 가지에 이른다고 한다. 현대의학은 이 병들의 원인이 우리 몸의 면역체계가 어떠한 이유로 스스로를 공격하므로 인해서 생기는 질환이라고 추정하는 것 이외에 정확한 원인도 알지 못할 뿐더러 치료 또한 대증요법에만 치중할 뿐 근본적 치료법은 아직 요원하기만 하다.
이 책의 저자 롭 던은 최근 선진국 사회에서 급증하고 있는 자가면역질환 중에서도 고통이 가장 심한 질병인 크론병을 예로 들며, 그 원인과 치료법에 대해 그의 생물학적 지식과 광범위한 연구 결과들을 바탕으로 새로운 가능성을 제시하고 있다. 우리나라에서도 최근 10년간 환자수가 4배 이상 급증하고 있는 염증성 대장질환 크론병에 대해 주류의사들은 서구식 식습관과 흡연 등이 원인이라고 말한다. 이 병이 처음 발병한 서구 선진국 사회에서 유행병처럼 번지고 있기 때문에 ‘그냥 그렇게 추측하는 것’ 뿐이다. 그러나 흡연이나 식습관은 이 병을 악화시킬 뿐 근본적인 원인은 되지 못한다. 크론병의 전제조건이 되는 것은 경제발전, 풍족함, 도시화, 부처럼 우리가 현대적이라고 여기는 것들이다. 이전에 인도와 중국에는 이 병이 없었지만 최근에는 일부에서 나타나고 있다. 과학자들은 이 크론병의 원인에 대해 다양한 가설들을 내놓았다. 그중 장-피에르 휴고Jean-Pierre Hugot는 냉장고에 살고 있는 세균을 크론병의 원인으로 생각했다. 몇몇 증거들이 이를 뒷받침 하고 있기도 하다. 그러나 이런 관점에서는 TV, 자동차, 세탁기를 갖는 것도 크론병과 관련이 있다는 결론에 도달한다. 어쨌든 이 가설을 뒤집을 명확한 근거는 현재까지 없다. 그러나